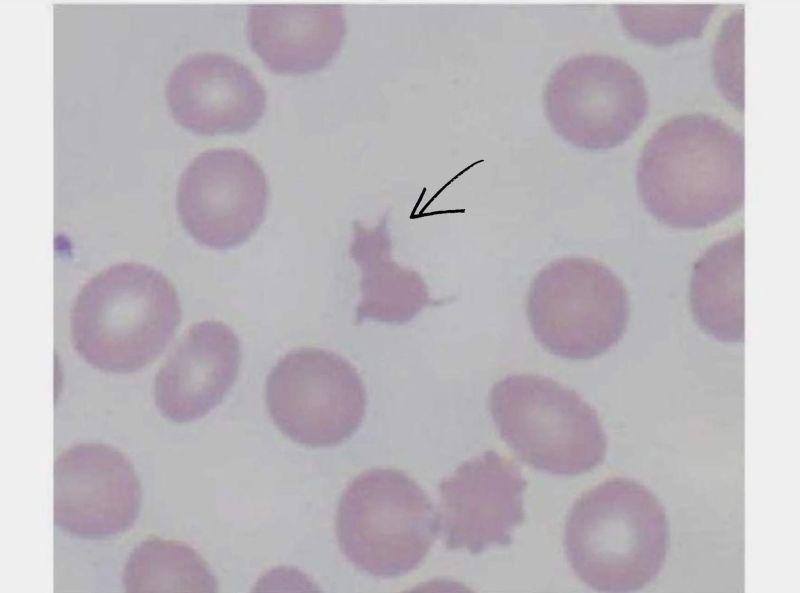
A ''Meow-cyte'' from Melaku Abay Muluneh or Why Microscopy Never Gets Old! 1 A ''Meow-cyte'' from Melaku Abay Muluneh or Why Microscopy Never Gets Old!

Melaku Abay Muluneh/LinkedIn
Nov 19, 2025, 16:09
A ”Meow-cyte” from Melaku Abay Muluneh or Why Microscopy Never Gets Old!
Melaku Abay Muluneh, Director and Chief Pathologist at Cerba Lancet Africa, shared on LinkedIn:
”Morphology Moment of the Day
Some peripheral smears came with an unexpected guest.
Here, one RBC fragment showed up with a spot-on cat silhouette, instantly earning the nickname “meow-cyte.”
These small surprises are part of what makes morphology so captivating.
These tiny details remind us why microscopy never gets old.
Colleagues:
What’s the most unusual or memorable shape you’ve spotted on a smear?”
Stay updated with Hemostasis Today.
-
Feb 23, 2026, 18:13Fight4Hematology Supports Research and Empowers the Next Generation – ASH
-
Feb 23, 2026, 17:59Wolfgang Miesbach: Real-World Evidence of Emicizumab on Joint Outcomes in Hemophilia A
-
Feb 23, 2026, 17:56Shiny K Kajal: The Transfusion Reaction We Often Miss
-
Feb 23, 2026, 17:53Radheshyam Meher: Contributing to the Transfusion Evidence Round-Up for International Childhood Cancer Day 2026
-
Feb 23, 2026, 17:46Mahesan Subramaniam: The Physiological Impact of Anger on Immunity
-
Feb 23, 2026, 17:42Bryan Fry: First Evidence That Bothrops atrox Venom Directly Activates Human Factor VII
-
Feb 23, 2026, 17:34Bastu Odoka: Why Blood Should NOT be Left at the Bedside to ‘Warm’
-
Feb 23, 2026, 17:28Henry Burkitt: Patients Are Challenging How the Medicines Policy System Works in England
-
Feb 23, 2026, 16:50Mutaz Al‑Sabah: Interesting Webinar on FH in Women is Now Available to Watch